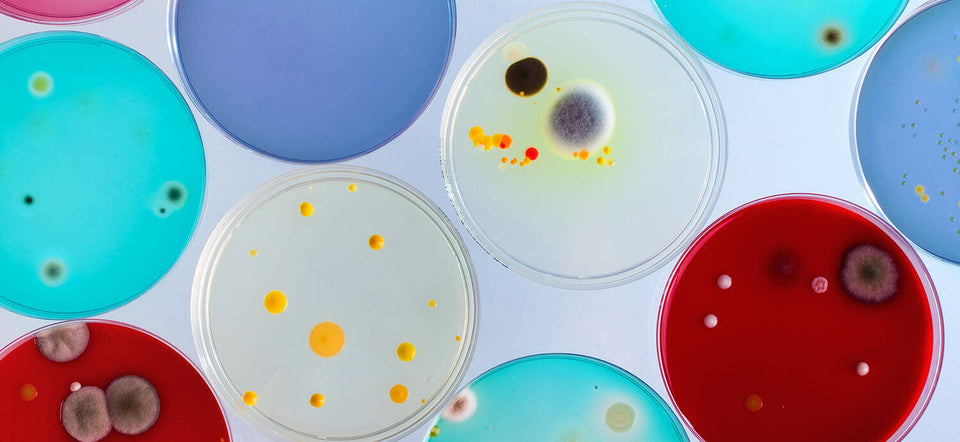

Yeast infections. Oh, the wonders of the human body! Let’s be honest, when it comes to yeast infections you’ve probably heard it all—stick to cotton underwear, don’t leave your bathing suit on for too long, eat yogurt, beware of certain kinds of birth control and antibiotics! The topic is a little oversaturated, am I right? Well, I’ve got some news for you—you haven’t heard it all, yet! Check out these three things you probably didn’t know about yeast and yeast infections:
-
Yeast Infections: Candida Fungus Loves Carbs
Who doesn’t love carbs?! But this is one of those times when a love of carbs isn’t so good for your body. Sorry, babes! Recent studies have found that diets higher in carbs are also linked to increased amounts of Candida in the body.1 So maybe pizza for breakfast isn’t the best idea. On the other hand, studies have also found that diets high in amino acids, protein and fatty acids are negatively associated with Candida!2 Which might just give you an excuse to eat more avocados! -
Men Get Yeast Infections, Too!
That’s right, ladies—we’re not the only ones who have to deal with the itch and burn of a yeast infection. Three cheers for equality! While the term “yeast infection” generally refers to a vaginal infection caused by Candida overgrowth, yeast infections can also occur on other parts of the body, including the penis. A yeast infection of the penis is called candida balanitis, or balanitis thrush.3 Doesn’t quite roll off the tongue, does it? -
Prevent Yeast Infection Symptoms: Change Pads and Tampons Often
Pretty straightforward, right? Yeast lives for dark, warm and moist environments. Literally. And we all know during that time of the month things get especially dark, warm and moist down there. Pads and tampons can make for an even cozier home for that pesky yeast, so make sure you’re changing them often! 2
Now wasn’t that a rollercoaster ride of new information!? Knowledge is power, , and when it comes to vaginal health, you can never know too much!







